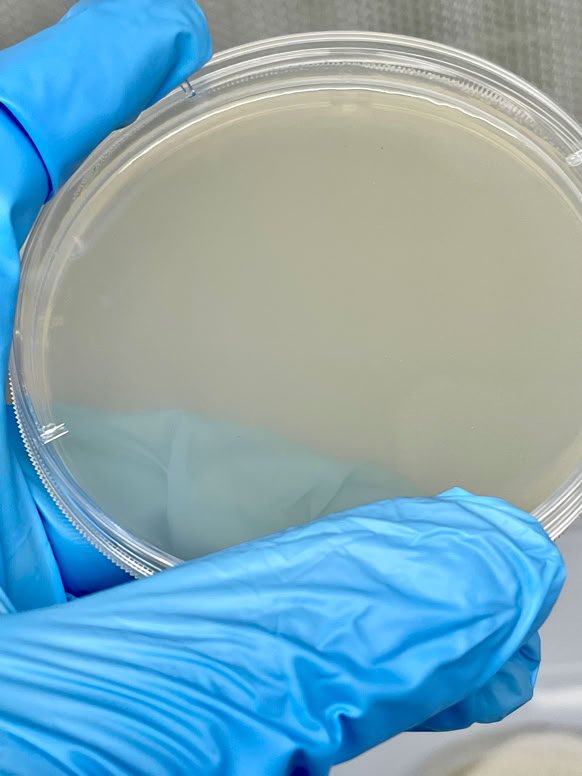

Vehicles
Electric
Shopping
My Account

TOOLS OF THE TRADE

Vehicles
Electric
Shopping
My Account

TOOLS OF THE TRADE
ALL PRODUCTS PREPARED IN ISO 6 CONTROLLED ENVIRONMENT

SAF
CLASSIC ORGANIC NUTRIENT AGAR POWDER for 1L FLUID

TAGAR ORGANIC NUTRIENT AGAR POWDER for 1L FLUID

TGELUXE HYDROGEL POWDER for 1L FLUID

Sterilized Modified Melon Norkrans
10 PACK
Specimen isolation growth medium.
Choose with or without Gentamicin.
Gamma Sterilized Petri Dish Sample Filled With your Choice of Sterilized Proprietary Organic Agar Formula
Single Dish Samples, shipped daily, weekdays only.

Gamma Sterilized Petri Dishes Filled With Sun Again Farm Proprietary Organic Agar Formula 10 PACK

TAGAR™
Proprietary Organic Formula Mycology Growth Medium
10 PACK

500 Gamma Sterilized Petri Dishes Filled With TAGAR™ Sun Again Farm Proprietary Organic Agar Formula

500 Gamma Sterilized Petri Dishes Filled With SAF CLASSIC Sun Again Farm Proprietary Organic Agar Formula

RCS3™
FOOD STORAGE SYSTEM
PORTABLE SCALABLE FOOD STORAGE SYSTEM

REFRIGERATOR

DRY
STORAGE

FREEZER

Control cost and quality with precise environment control supported by Carrier Thinline® systems. Ensure stable uptime with integrated power backup systems supported by SMA®. Robust food storage supporting your operational readiness anywhere.
FOOD AND POWER WHERE YOU NEED IT.

Currently accepting applications.
Most projects delivered within 8 months.


Comfy and cozy feet in every season. Put a little spring in your step.




Includes enough material that you can make 3 to 4 pairs for all your different shoes and boots and enough to get you thru the winter.
Fantastic thermal retention at the foot where it matters. Keeps the warmth of the blood in the feet.
Helps reduce moisture at the foot while maintaining a stable temperature, excellent impermeable vapor barrier at 0.011 perms (impermeable). Doesn’t wick moisture.
100% fungi resistant, meets ASTMC1338.



For use in all types of closed toe shoes and boots, composite toe, and steel toe boots and shoes. Great for young kids shoes.
Cut them yourself to fit your insole size.
Conforms to underside of your orthopedic insoles. Simply place it under existing insoles.
After few hours of walking, Warmiums™ conforms to the shape of the underside of your existing insole.
Comfy and cozy in every season. This product was developed here at Sun Again Farm in Arizona, and has been tested all over the world for many years.
Works great in the cold for keeping your natural body heat at the foot.
Works great in hot weather as thermal isolation keeping the heat out, makes hot roof work much more comfortable and winter motorcycle rides more confident.

Lifespan in your shoes will vary, similar to most name brand insoles.
Best foot health in our opinion is maintained by always replacing both your upper insoles and Warmiums™ every two months if you wear them everyday.
You should always clean the insides of your shoes too, as regularly as you wash your feet.
This kit includes enough material to make at least 3 to 4 pairs depending on shoe size, enough to last all winter.
Three 16.5 inch x 14 inch pads are included in the kit.
Each pad is 0.20 inch thick.



SUN AGAIN FARM LLC.
200 S Curtis Ave. #706
WILLCOX, AZ 85643-2144
niko@sunagainfarm.com
(520) 425-4912
TEXT PREFERED, CALLS ARE SCREENED